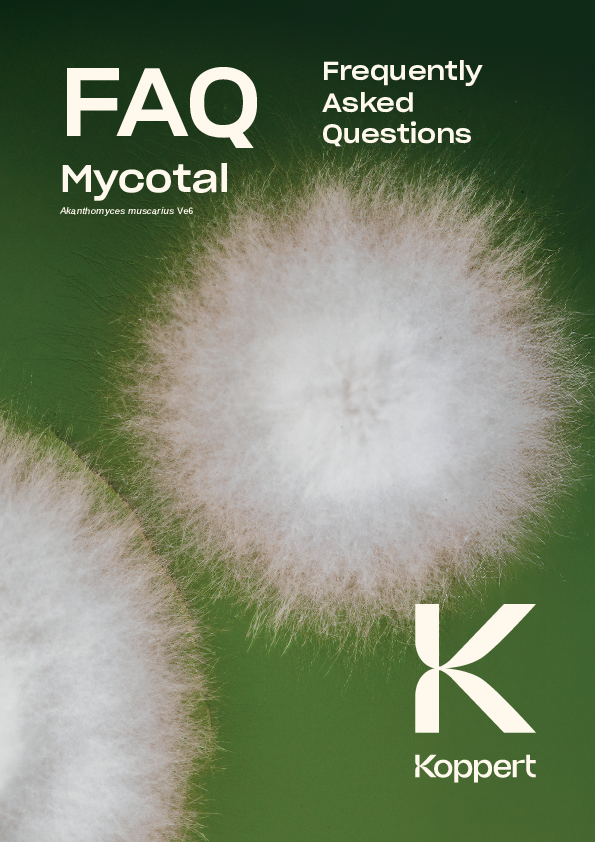
FAQ Mycotal

Use for
Crops
Vegetables, ornamentals, nursery trees and soft fruit in protected cultivation.
"The general conditions of Koppert (Koppert B.V. and/or of its affiliated companies) apply. Only
use products that are permitted in your country/state and crop. Always comply with the conditions
specified in local product registrations. Koppert cannot be held liable for unauthorized use.
Koppert is not liable for any loss of quality if the product is stored for longer than recommended
and/or under incorrect conditions."